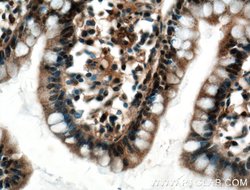
EWS Rabbit anti-Human, Mouse, Rat, Polyclonal, Proteintech 150 &mu;L; Unconjugated:Antibodies,
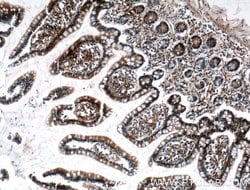
EWS Rabbit anti-Human, Mouse, Rat, Polyclonal, Proteintech 150 &mu;L; Unconjugated:Antibodies,

missing translation for 'onlineSavingsMsg'
Learn More
Learn More
EWS Rabbit anti-Human, Mouse, Rat, Polyclonal, Proteintech
Rabbit Polyclonal Antibody
Brand: Proteintech 55191-1-AP-150UL
This item is not returnable.
View return policy
Description
This antibody is specific to EWS. A 90 kDa band also could be detected.
This gene encodes a multifunctional protein that is involved in various cellular processes, including gene expression, cell signaling, and RNA processing and transport. The protein includes an N-terminal transcriptional activation domain and a C-terminal RNA-binding domain. Chromosomal translocations between this gene and various genes encoding transcription factors result in the production of chimeric proteins that are involved in tumorigenesis. These chimeric proteins usually consist of the N-terminal transcriptional activation domain of this protein fused to the C-terminal DNA-binding domain of the transcription factor protein. Mutations in this gene, specifically a ttranslocation, are known to cause Ewing sarcoma as well as neuroectodermal and various other tumors. Alternative splicing of this gene results in multiple transcript variants. Related pseudogenes have been identified on chromosomes 1 and 14.Specifications
| EWS | |
| Polyclonal | |
| Unconjugated | |
| EWSR1 | |
| EWS, EWS oncogene, EWSR1, RNA binding protein EWS | |
| Rabbit | |
| Antigen Affinity Chromatography | |
| RUO | |
| 14030, 2130, 289752 | |
| -20°C | |
| Liquid |
| Immunohistochemistry (Paraffin), Western Blot | |
| 0.57 mg/mL | |
| PBS with 50% glycerol and 0.02% sodium azide; pH 7.3 | |
| Q01844, Q61545 | |
| Ewsr1 | |
| Peptide | |
| 150 μL | |
| Primary | |
| Human, Mouse, Rat | |
| Antibody | |
| IgG |
Product Content Correction
Your input is important to us. Please complete this form to provide feedback related to the content on this product.
Product Title
Spot an opportunity for improvement?Share a Content Correction